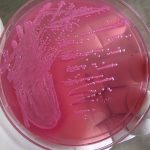
E. coli on MacConkey agar enterobacteriaceae

Tag: Enterobacteriaceae
Serratia ficaria: Introduction, Morphology, Pathogenicity, Lab Diagnosis, Treatment,Prevention, and Keynotes
 Introduction Serratia ficaria is a bacterial species belonging to the...
Introduction Serratia ficaria is a bacterial species belonging to the...
Enterobacteriaceae: Introduction, Phenotypic Features and Related Videos
Enterobacteriaceae The family Enterobacteriaceae is a very large group...
Enterobacteriaceae The family Enterobacteriaceae is a very large group...
